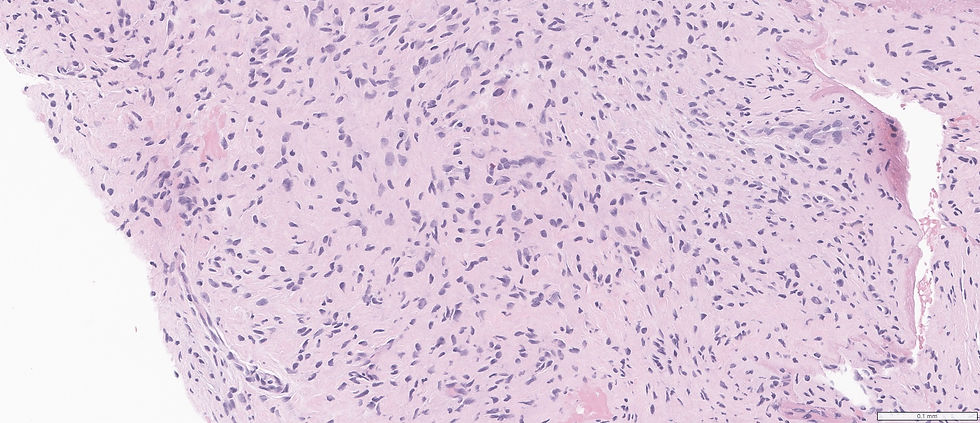

Case 105
- Wangpan Shi
- May 11
- 1 min read
A 55-year-old male with a 2.3 cm left lip lesion.

What's your diagnosis?
A: schwannoma
B: desmoid
C: nodular fasciitis
D: neurofibroma
E: MPNST
Answer
The correct answer is D. Look at the wavy nuclei and mast cells.
Case credit: UCSD pathology
Author: Wangpan Jackson Shi, MD

Comments